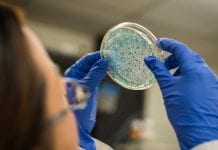
The world of microbiomes is about to get much better The world of microbiomes is about to get much better

Medical Research Related News
Beating Childhood Cancer: minimising deaths and late effects
SIOP Europe and CCI Europe have the ambitious goal of beating childhood cancer, with the aim of curing more and curing better – towards...
Let’s get acquainted with The Digital Healthcare Show
The double award-winning Digital Healthcare Show will return on 26-27 June 2019 to London with the goal of reinvigorating the digital transformation plans of...
First-ever interactive audio map conveying emotion
According to University of California, those spontaneous nonverbal exclamations we make speak volumes, expressing more about what we're feeling than previously understood.
Everything from elation...
A combination of treatments may help fight breast cancer
According to researchers from the University of Helsinki, Finland, cancer cells can be attacked with a ‘drug cocktail’ which can potentially help to fight...
The metallodrug: could this be the next antitumor drug?
Some types of cancer cannot be treated with classic chemotherapy, so a team of scientists are working on a metallodrug, which has the potential...
Novartis Pharmaceuticals revolutionising data use
During their annual results briefing in Switzerland, Novartis Pharmaceuticals, the innovative healthcare solutions company, announced their plan to transform healthcare.
Novartis emphasised the integration of...
Can serotonin neurons give you cat-like reflexes?
Known for its role in relieving depression, serotonin neurons could also help the brain execute instantaneous, appropriate behaviours in emergency situations.
According to a Cornell...
TILRAY: the medical cannabis research global leader
Medical cannabis is rapidly gaining momentum across the globe, and Tilray Inc. is pioneering the production, research, and distribution of medical cannabis.
This ebook explores...
What do you know about the One Health concept?
One Health is a concept that recognises interlinks between human health, animal health and the environment, and now it’s time for a more aligned...
University Hospital Basel forms new alliance delivering enhanced patient care
University Hospital Basel, Switzerland, and award-winning UK medical 3D printing firm, axial3D have formed a new alliance to deliver improved patient care.
The leading medical...
Inpatient sleep interruptions to be reduced by SIESTA project
Although patients may spend much of their time sitting in a chair or recovering in bed, inpatient sleep interruptions is common – but a...
Adenosine deaminases function may be the molecular radar we need
Adenosine deaminases are a family of three enzymes encoded by the ADAR genes, and researchers have found that editing enzyme promotes tumour suppressor loss...
Male-female brain differences may be unlocked with new findings
Columbia University, USA, researchers have identified a genetic pathway to sexual maturation in roundworms that show male-female brain differences.
Researchers have identified a group of...
Excess body weight and the world of cancer
According to new studies, excess body weight is an established cause of cancer, currently known to be linked to 13 cancers.
A new study looking...
Phantom limb pain treatment: rerouting nerves during amputation
Ohio State University find life-altering benefits by rerouting nerves during amputation - could this be a form of phantom limb pain treatment?
Doctors at The...
We’re one step closer to giving artificial intelligence human hearing
Researchers have simulated the process of the sensory sounds coding for artificial intelligence by modelling human hearing.
Scientists of Peter the Great St. Petersburg Polytechnic...
The world of microbiomes is about to get much better
The newly European-funded project MicrobiomeSupport held its kick-off meeting, with the goal of enhancing research regarding microbiomes.
The meeting held on 28 November 2018 in...
EIT Health focusing on digital biomarkers and mental & brain health
EIT Health aims to create new business ventures addressing the way in which mental and brain health is managed and the use of digital...
CAR T cell therapy – axicabtagene ciloleucel ready for treatment
The CAR T cell therapy, axicabtagene ciloleucel received European Marketing Authorisation for the treatment of adult patients suffering with lymphoma.
Kite, a Gilead Company, announced...
The retinal response to artificial illumination and screen time
Scientists uncover how certain retinal cells respond to artificial illumination - discovering screen time exposure results in sleep disruption.
For many individuals, the amount of...